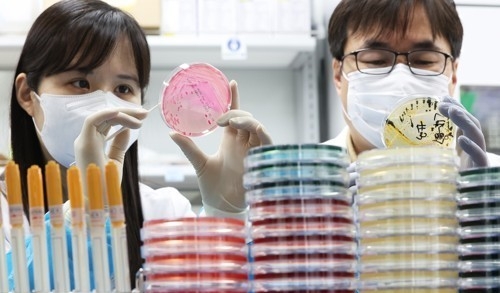

충청권 군부대 여러 곳에서 장병 수백 명이 식중독 의심 증상을 보여 보건당국이 역학 조사에 나섰습니다.
3일 충북도에 따르면 이날 오후 4시 기준 청주와 보은 등 도내 9개 시·군 13개 부대에서 장병 140여 명이 설사와 구토 등 증상을 보였습니다.
대부분은 병원 치료를 받은 뒤 호전된 상태로 알려졌습니다.
같은 날 충남 보령·태안과 대전, 세종 등지에서도 장병 50여 명이 비슷한 증상을 호소했습니다.
이에 따라 충청권 전체 환자는 190명에 달합니다.
보건당국은 전날 저녁 식사가 공통 요인일 가능성에 주목하고 있습니다.
특히 대전 군수지원단이 해당 부대들에 식자재를 납품한 사실을 확인했습니다.
당국은 납품·배송 과정과 식수 상태 등을 조사하고 있습니다.
해당 군수지원단은 충청권 전역 군부대의 식자재 구매와 처리를 담당하고 있으며 배송은 민간업체에 위탁해 왔습니다.
군 당국은 예하 부대별로 추가 증상자가 있는지 확인하고 있습니다.
또 시료를 채취해 보건당국에 검사를 의뢰했습니다.
충북도는 각 시·군 보건소와 협력해 역학조사를 진행 중입니다.
정확한 결과는 2주 뒤에 나올 전망입니다.
보건당국은 조사 결과에 따라 감염 경로를 규명하고 후속 조치에 나선다는 방침입니다.
























































댓글
(0)